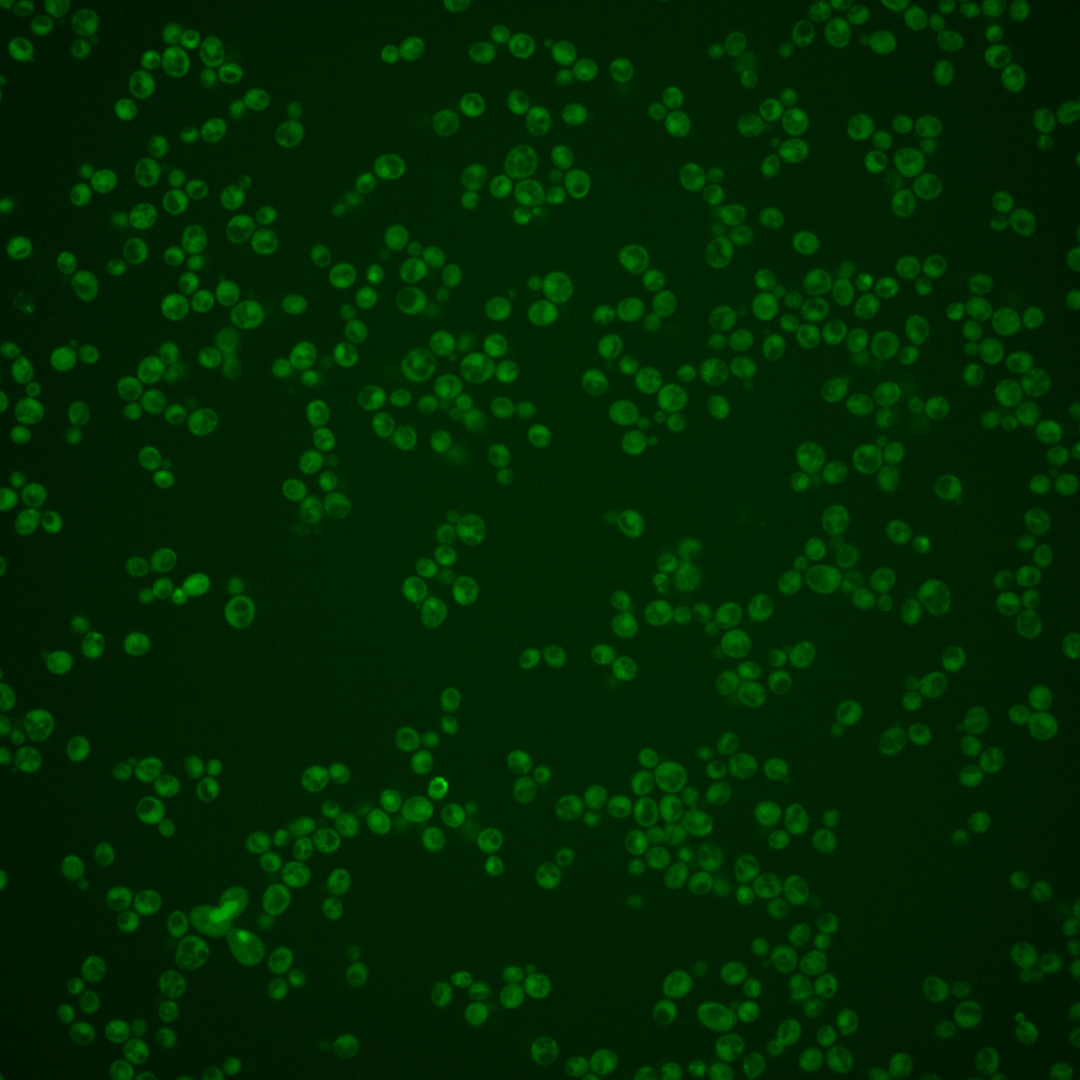
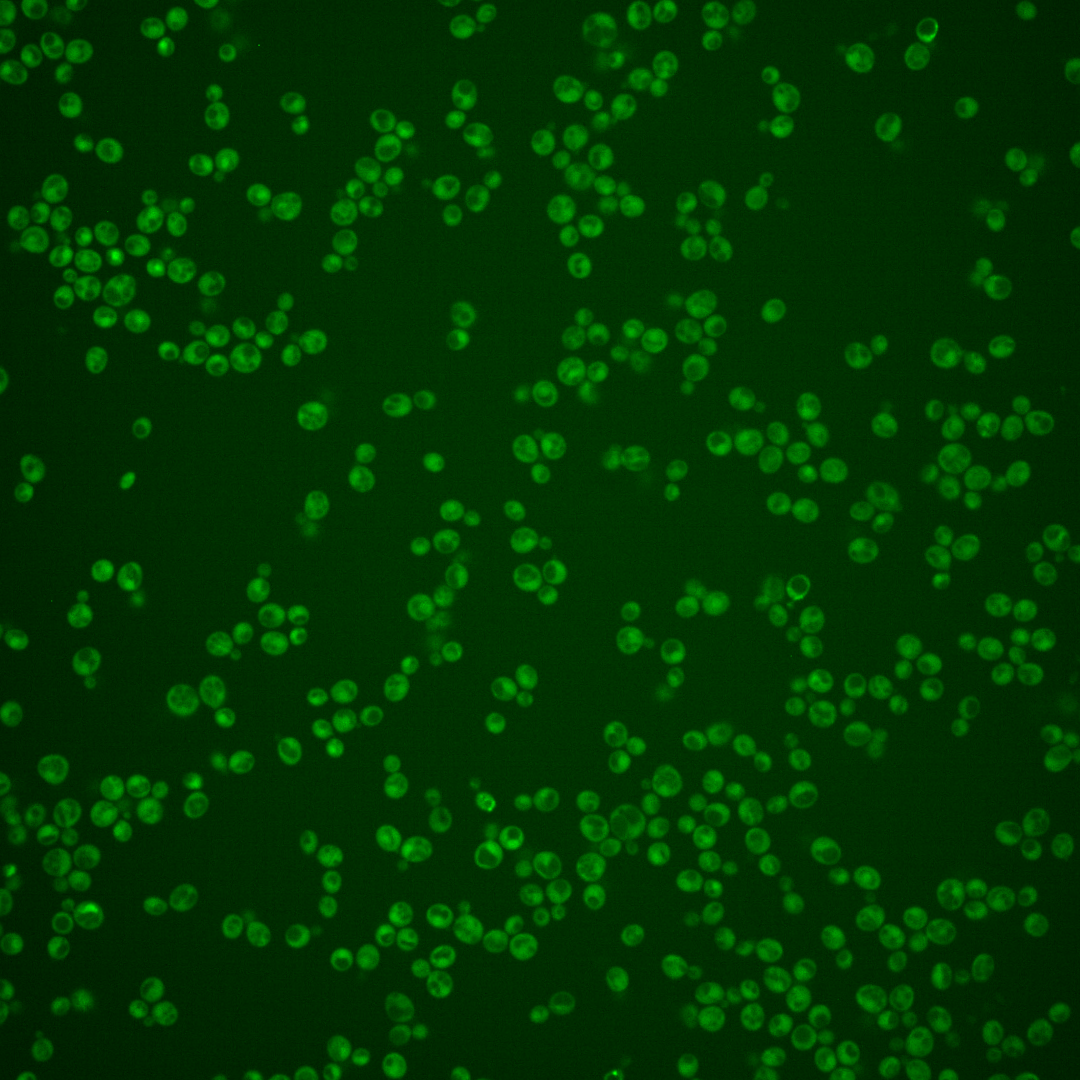
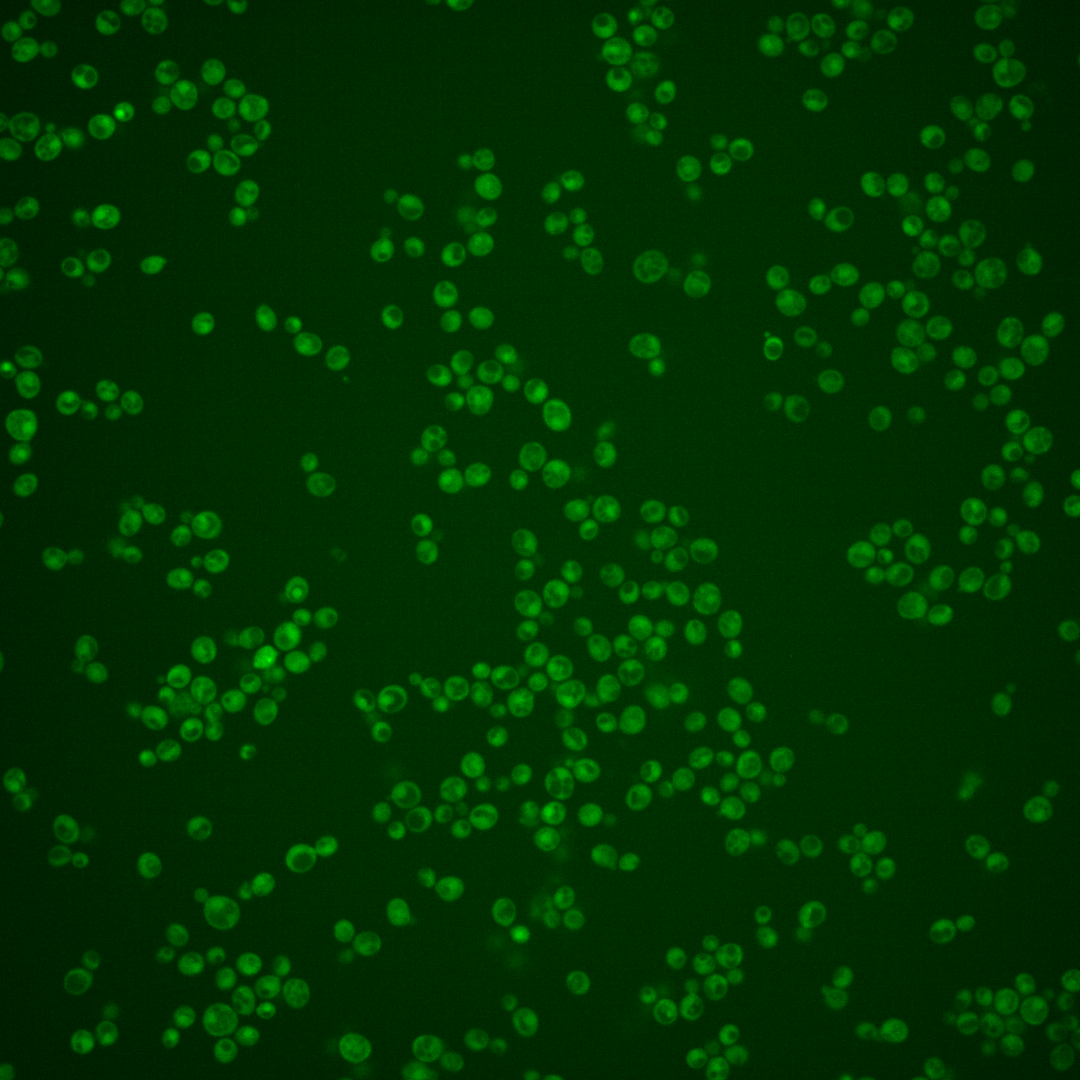
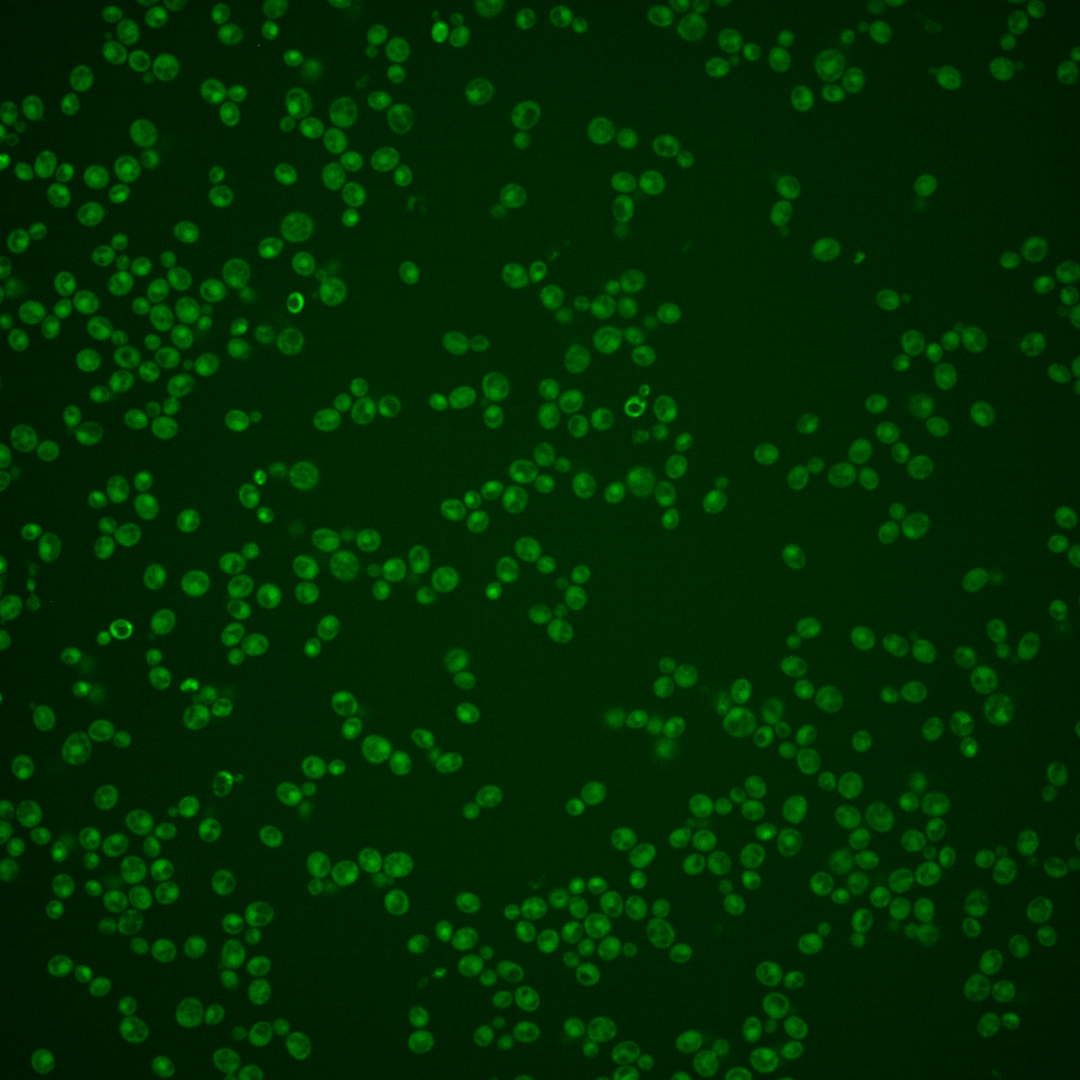

| Standard name | |
|---|---|
| Human Ortholog | |
| Description | Modulator of cell separation and mitotic exit; inhibits separation through Ub-dependent Ace2p proteolysis; part of a daughter-specific switch induced by the mitotic exit network that inhibits exit and resets the cell cycle after the execution of MEN function, blocking Tem1p and Cdc15 association; required for chromosome stability and multiple mitotic checkpoints; regulated by SCF; haploid transcription regulated by Ste12p; contains 12 degenerate leucine-rich repeat motifs and an atypical F-box |
Micrographs




















































































Sub-cellular Localization
Yeast GFP Assignment
Protein Abundance
Localization Change
External localization resources
| ensLOC | DeepLoc | |||||||||||||||||||||||
|---|---|---|---|---|---|---|---|---|---|---|---|---|---|---|---|---|---|---|---|---|---|---|---|---|
| Localization | WT1 | WT2 | WT3 | RAP60 | RAP140 | RAP220 | RAP300 | RAP380 | RAP460 | RAP540 | RAP620 | RAP700 | HU80 | HU120 | HU160 | rpd3Δ_1 | rpd3Δ_2 | rpd3Δ_3 | WT1 | WT2 | WT3 | AF100 | AF140 | AF180 |
| Cortical Patches | 0 | 0 | 0 | 0 | 0 | 0 | 0 | 0 | 0 | 0 | 0 | 0 | 0 | 0 | 0 | – | 0 | 0 | 1 | 5 | 12 | 0 | 3 | 8 |
| Bud | 3 | 1 | 3 | 0 | 2 | 10 | 7 | 9 | 10 | 11 | 6 | 4 | 0 | 2 | 0 | – | 0 | 0 | 6 | 20 | 8 | 2 | 5 | 10 |
| Bud Neck | 0 | 1 | 1 | 1 | 3 | 3 | 4 | 8 | 1 | 3 | 0 | 2 | 0 | 0 | 0 | – | 2 | 3 | 0 | 2 | 6 | 0 | 1 | 4 |
| Bud Site | 0 | 0 | 0 | 0 | 0 | 2 | 0 | 0 | 5 | 2 | 2 | 2 | 0 | 0 | 0 | – | 0 | 0 | – | – | – | – | – | – |
| Cell Periphery | 2 | 1 | 1 | 2 | 1 | 0 | 0 | 2 | 0 | 0 | 0 | 2 | 1 | 0 | 1 | – | 11 | 6 | 0 | 2 | 2 | 1 | 1 | 3 |
| Cytoplasm | 102 | 366 | 395 | 222 | 263 | 310 | 351 | 298 | 240 | 279 | 78 | 74 | 266 | 338 | 364 | – | 525 | 507 | 84 | 260 | 251 | 136 | 221 | 217 |
| Endoplasmic Reticulum | 0 | 0 | 1 | 0 | 2 | 0 | 0 | 1 | 0 | 0 | 5 | 6 | 2 | 0 | 4 | – | 49 | 42 | 1 | 1 | 4 | 1 | 3 | 5 |
| Endosome | 3 | 3 | 1 | 0 | 3 | 2 | 0 | 0 | 1 | 1 | 0 | 0 | 0 | 3 | 0 | – | 6 | 5 | 1 | 4 | 14 | 0 | 3 | 4 |
| Golgi | 0 | 0 | 1 | 0 | 1 | 1 | 0 | 0 | 0 | 0 | 0 | 0 | 0 | 0 | 0 | – | 1 | 0 | 0 | 1 | 1 | 1 | 3 | 0 |
| Mitochondria | 24 | 11 | 13 | 29 | 43 | 190 | 235 | 179 | 265 | 317 | 152 | 221 | 0 | 2 | 0 | – | 10 | 10 | 13 | 28 | 89 | 8 | 13 | 21 |
| Nucleus | 17 | 39 | 3 | 0 | 2 | 2 | 3 | 2 | 3 | 2 | 1 | 1 | 4 | 0 | 0 | – | 1 | 2 | 29 | 51 | 5 | 2 | 10 | 6 |
| Nuclear Periphery | 0 | 0 | 0 | 0 | 0 | 0 | 0 | 0 | 0 | 1 | 0 | 1 | 0 | 0 | 0 | – | 0 | 0 | 0 | 0 | 0 | 0 | 0 | 0 |
| Nucleolus | 1 | 0 | 0 | 0 | 1 | 1 | 0 | 1 | 0 | 2 | 1 | 1 | 1 | 0 | 0 | – | 0 | 1 | 0 | 0 | 0 | 0 | 0 | 0 |
| Peroxisomes | 0 | 0 | 0 | 0 | 1 | 0 | 0 | 0 | 0 | 0 | 0 | 0 | 0 | 0 | 0 | – | 1 | 2 | 0 | 1 | 1 | 0 | 0 | 0 |
| SpindlePole | 1 | 0 | 2 | 0 | 1 | 5 | 8 | 13 | 7 | 8 | 2 | 5 | 0 | 0 | 0 | – | 4 | 1 | 22 | 32 | 12 | 4 | 12 | 10 |
| Vac/Vac Membrane | 20 | 60 | 19 | 1 | 3 | 5 | 8 | 6 | 5 | 5 | 1 | 3 | 5 | 0 | 1 | – | 35 | 22 | 13 | 43 | 20 | 6 | 14 | 28 |
| Unique Cell Count | 153 | 450 | 419 | 230 | 298 | 426 | 514 | 446 | 417 | 491 | 204 | 264 | 274 | 342 | 369 | 553 | 534 | 182 | 465 | 446 | 171 | 304 | 333 | |
| Labelled Cell Count | 173 | 482 | 440 | 255 | 326 | 531 | 616 | 519 | 537 | 631 | 248 | 322 | 279 | 345 | 370 | 645 | 601 | 182 | 465 | 446 | 171 | 304 | 333 | |
Yeast GFP Assignment
Protein Abundance
| Screen | WT1 | WT2 | WT3 | RAP60 | RAP140 | RAP220 | RAP300 | RAP380 | RAP460 | RAP540 | RAP620 | RAP700 | HU80 | HU120 | HU160 | rpd3Δ_1 | rpd3Δ_2 | rpd3Δ_3 | AF100 | AF140 | AF180 |
|---|---|---|---|---|---|---|---|---|---|---|---|---|---|---|---|---|---|---|---|---|---|
| Mean Cell GFP Intensity (1e-4) | 3.9 | 4.3 | 4.0 | 3.5 | 3.8 | 3.2 | 2.6 | 3.0 | 2.9 | 2.5 | 2.7 | 2.5 | 4.5 | 4.2 | 4.4 | 4.8 | 5.9 | 5.4 | 4.3 | 4.5 | 5.0 |
| Std Deviation (1e-4) | 1.4 | 0.8 | 1.6 | 1.5 | 1.8 | 1.4 | 0.7 | 1.0 | 1.1 | 0.7 | 0.6 | 0.7 | 1.4 | 1.2 | 1.6 | 1.9 | 1.9 | 2.0 | 1.9 | 1.9 | 1.5 |
| Intensity Change (Log2) | – | – | – | -0.18 | -0.07 | -0.31 | -0.63 | -0.43 | -0.47 | -0.66 | -0.53 | -0.65 | 0.16 | 0.07 | 0.14 | 0.28 | 0.57 | 0.45 | 0.1 | 0.17 | 0.32 |
Localization Change
| Localization | RAP60 | RAP140 | RAP220 | RAP300 | RAP380 | RAP460 | RAP540 | RAP620 | RAP700 | HU80 | HU120 | HU160 | rpd3Δ_1 | rpd3Δ_2 | rpd3Δ_3 |
|---|---|---|---|---|---|---|---|---|---|---|---|---|---|---|---|
| Actin | – | – | – | – | – | – | – | – | – | – | – | – | – | – | – |
| Bud | – | – | – | – | – | – | – | – | – | – | – | – | – | 0 | 0 |
| Bud Neck | – | – | – | – | – | – | – | – | – | – | – | – | – | 0 | 0 |
| Bud Site | – | – | – | – | – | – | – | – | – | – | – | – | – | 0 | 0 |
| Cell Periphery | – | – | – | – | – | – | – | – | – | – | – | – | – | 0 | 0 |
| Cyto | – | – | – | – | – | – | – | – | – | – | – | – | – | – | – |
| Endoplasmic Reticulum | – | – | – | – | – | – | – | – | – | – | – | – | – | 0 | 0 |
| Endosome | – | – | – | – | – | – | – | – | – | – | – | – | – | 0 | 0 |
| Golgi | – | – | – | – | – | – | – | – | – | – | – | – | – | 0 | 0 |
| Mitochondria | – | – | – | – | – | – | – | – | – | – | – | – | – | 0 | 0 |
| Nuclear Periphery | – | – | – | – | – | – | – | – | – | – | – | – | – | 0 | 0 |
| Nuc | – | – | – | – | – | – | – | – | – | – | – | – | – | – | – |
| Nucleolus | – | – | – | – | – | – | – | – | – | – | – | – | – | 0 | 0 |
| Peroxisomes | – | – | – | – | – | – | – | – | – | – | – | – | – | 0 | 0 |
| SpindlePole | – | – | – | – | – | – | – | – | – | – | – | – | – | 0 | 0 |
| Vac | – | – | – | – | – | – | – | – | – | – | – | – | – | – | – |
| Cortical Patches | – | – | – | – | – | – | – | – | – | – | – | – | – | 0 | 0 |
| Cytoplasm | – | – | – | – | – | – | – | – | – | – | – | – | – | 0 | 0 |
| Nucleus | – | – | – | – | – | – | – | – | – | – | – | – | – | 0 | 0 |
| Vacuole | – | – | – | – | – | – | – | – | – | – | – | – | – | 1.2 | -0.3 |
External localization resources
Images






























Protein Concentration and Protein Localization Data
| R1 | R2 | R3 | ||||||||||||||||
|---|---|---|---|---|---|---|---|---|---|---|---|---|---|---|---|---|---|---|
| G1 Pre-START | G1 Post-START | S/G2 | Metaphase | Anaphase | Telophase | G1 Pre-START | G1 Post-START | S/G2 | Metaphase | Anaphase | Telophase | G1 Pre-START | G1 Post-START | S/G2 | Metaphase | Anaphase | Telophase | |
| Concentration | 3.1693 | 1.2017 | 1.3169 | 1.1106 | 0.343 | 1.8065 | 2.9311 | 2.3238 | 2.4789 | 2.6638 | 2.0554 | 2.406 | 4.2038 | 2.9067 | 3.1727 | 2.9359 | 3.3377 | 3.1537 |
| Actin | 0.1846 | 0.0009 | 0.0001 | 0.0011 | 0.0041 | 0.0016 | 0.0059 | 0.0029 | 0.0287 | 0.0008 | 0.003 | 0.0052 | 0.0109 | 0.0005 | 0.0146 | 0.0004 | 0.003 | 0.0019 |
| Bud | 0.007 | 0.0004 | 0 | 0.0062 | 0.0018 | 0.0058 | 0.0004 | 0.017 | 0.0156 | 0.0002 | 0.0002 | 0.0018 | 0.0005 | 0.0066 | 0.0036 | 0.0004 | 0.007 | 0.0015 |
| Bud Neck | 0.0043 | 0.0001 | 0 | 0.0001 | 0.0002 | 0.0067 | 0.0008 | 0.0008 | 0.0006 | 0 | 0.0001 | 0.0015 | 0.0088 | 0.0005 | 0.0026 | 0.0005 | 0.0001 | 0.0039 |
| Bud Periphery | 0.0344 | 0.0009 | 0.0001 | 0.0044 | 0.0038 | 0.0072 | 0.0005 | 0.0147 | 0.0044 | 0.0007 | 0.0003 | 0.001 | 0.0008 | 0.0079 | 0.0087 | 0.0004 | 0.0104 | 0.0019 |
| Bud Site | 0.0184 | 0.0013 | 0.0001 | 0.0019 | 0.001 | 0.0093 | 0.0027 | 0.0263 | 0.0112 | 0 | 0.0006 | 0.0003 | 0.0067 | 0.0151 | 0.0092 | 0.0007 | 0.0009 | 0.0006 |
| Cell Periphery | 0.0052 | 0.0003 | 0.0002 | 0.0001 | 0.0001 | 0.0003 | 0.0002 | 0.001 | 0.0004 | 0.0001 | 0.0001 | 0.0001 | 0.0005 | 0.0004 | 0.0007 | 0.0001 | 0.0003 | 0.0003 |
| Cytoplasm | 0.1914 | 0.0986 | 0.0315 | 0.0896 | 0.017 | 0.1474 | 0.2142 | 0.1554 | 0.1082 | 0.0399 | 0.1542 | 0.2222 | 0.1769 | 0.0819 | 0.0854 | 0.0933 | 0.0597 | 0.2033 |
| Cytoplasmic Foci | 0.0198 | 0.0024 | 0.0018 | 0.0049 | 0.0083 | 0.0101 | 0.0607 | 0.0051 | 0.0171 | 0.0036 | 0.0049 | 0.0137 | 0.0326 | 0.0069 | 0.0106 | 0.0425 | 0.0075 | 0.0136 |
| Eisosomes | 0.0019 | 0.0001 | 0.0002 | 0.0004 | 0.0004 | 0.0001 | 0.0004 | 0.0003 | 0.0003 | 0.0002 | 0.0001 | 0.0001 | 0.0004 | 0.0002 | 0.0003 | 0.0002 | 0.0001 | 0.0001 |
| Endoplasmic Reticulum | 0.0216 | 0.0014 | 0.0004 | 0.0011 | 0.0003 | 0.002 | 0.0043 | 0.0038 | 0.0019 | 0.0006 | 0.0009 | 0.0021 | 0.0102 | 0.0023 | 0.0044 | 0.0013 | 0.001 | 0.0022 |
| Endosome | 0.0236 | 0.0005 | 0.0002 | 0.0005 | 0.0002 | 0.0015 | 0.0296 | 0.0077 | 0.0035 | 0.0004 | 0.0179 | 0.0051 | 0.0223 | 0.0015 | 0.0142 | 0.0161 | 0.0018 | 0.0027 |
| Golgi | 0.011 | 0.0001 | 0 | 0.0002 | 0.0002 | 0.0002 | 0.0158 | 0.0022 | 0.0029 | 0.0001 | 0.0224 | 0.004 | 0.0036 | 0.0001 | 0.0075 | 0.0016 | 0.0047 | 0.0003 |
| Lipid Particles | 0.0131 | 0.0002 | 0.0002 | 0.0003 | 0.0007 | 0.0004 | 0.0171 | 0.0005 | 0.0084 | 0.0003 | 0.0009 | 0.0026 | 0.0156 | 0.0003 | 0.0041 | 0.0019 | 0.0097 | 0.0008 |
| Mitochondria | 0.0299 | 0.0002 | 0.0002 | 0.0009 | 0.001 | 0.0011 | 0.0083 | 0.0036 | 0.0129 | 0.0004 | 0.0138 | 0.0022 | 0.0018 | 0.0007 | 0.0043 | 0.0005 | 0.0289 | 0.0009 |
| None | 0.3011 | 0.8906 | 0.9638 | 0.8622 | 0.9449 | 0.5756 | 0.4482 | 0.7307 | 0.7491 | 0.9475 | 0.778 | 0.6439 | 0.5325 | 0.8468 | 0.795 | 0.8285 | 0.8305 | 0.6766 |
| Nuclear Periphery | 0.0171 | 0.0004 | 0.0002 | 0.0024 | 0.0007 | 0.0039 | 0.0091 | 0.0027 | 0.0009 | 0.0007 | 0.0003 | 0.0067 | 0.0097 | 0.002 | 0.0083 | 0.0006 | 0.0002 | 0.003 |
| Nucleolus | 0.007 | 0.0001 | 0.0001 | 0.001 | 0.0012 | 0.003 | 0.0017 | 0.0009 | 0.0007 | 0.0003 | 0.0001 | 0.0013 | 0.0014 | 0.0009 | 0.0006 | 0.0004 | 0.0001 | 0.0011 |
| Nucleus | 0.0117 | 0.0005 | 0.0002 | 0.0058 | 0.0016 | 0.199 | 0.1373 | 0.0162 | 0.0072 | 0.0005 | 0.0003 | 0.0642 | 0.1401 | 0.0169 | 0.0118 | 0.0009 | 0.0003 | 0.0714 |
| Peroxisomes | 0.0107 | 0.0001 | 0.0001 | 0.0005 | 0.0014 | 0.0002 | 0.03 | 0.0004 | 0.0227 | 0.0002 | 0.0005 | 0.0031 | 0.0099 | 0.0004 | 0.0043 | 0.0017 | 0.033 | 0.0008 |
| Punctate Nuclear | 0.0298 | 0.0003 | 0.0003 | 0.0157 | 0.0106 | 0.0213 | 0.0095 | 0.0037 | 0.0015 | 0.0027 | 0.0003 | 0.0173 | 0.012 | 0.0053 | 0.0019 | 0.0054 | 0.0003 | 0.011 |
| Vacuole | 0.0448 | 0.0005 | 0.0002 | 0.0005 | 0.0002 | 0.0029 | 0.0027 | 0.003 | 0.0013 | 0.0006 | 0.0007 | 0.0012 | 0.0023 | 0.0026 | 0.0056 | 0.0022 | 0.0003 | 0.0019 |
| Vacuole Periphery | 0.0115 | 0.0001 | 0 | 0.0002 | 0.0001 | 0.0004 | 0.0007 | 0.001 | 0.0004 | 0.0003 | 0.0005 | 0.0005 | 0.0007 | 0.0003 | 0.0023 | 0.0002 | 0.0001 | 0.0004 |
Sequencing Data
| R1 | R2 | |||||||||
|---|---|---|---|---|---|---|---|---|---|---|
| G1 Post-START | S/G2 | Metaphase | Anaphase | Telophase | G1 Post-START | S/G2 | Metaphase | Anaphase | Telophase | |
| Gene Expression | 15.7152 | 14.3473 | 39.9237 | 153.9837 | 119.6512 | 15.3723 | 15.111 | 16.9301 | 85.2862 | 155.6867 |
| Translational Efficiency | 0.1324 | 0.1742 | 0.2881 | 0.2099 | 0.3775 | 0.1662 | 0.1473 | 0.1551 | 0.2286 | 0.3435 |
Hit Data
| Dataset | Hit |
|---|---|
| Protein Concentration | ✘ |
| Protein Localization | ✘ |
| Gene Expression | ✔ |
| Translational Efficiency | ✘ |
Endocytosis
| Temp | Actin Patch (Sac6-tdTomato) | Cortical Patch (Sla1-GFP) | Late Endosome (Snf7-GFP) | Vacuole (Vph1-GFP) |
|---|---|---|---|---|
| 37℃ | ||||
| RT |
Cell Cycle Omics
CYCLoPs (Amn1-GFP)
| Gene / Allele | Actin Patch (Sac6-tdTomato) | Cortical Patch (Sla1-GFP) | Late Endosome (Snf7-GFP) | Vacuole (Sac6-tdTomato) |
|---|
| Gene | Images |
|---|
| Gene | Images |
|---|
Images are not yet available
Images are not yet available